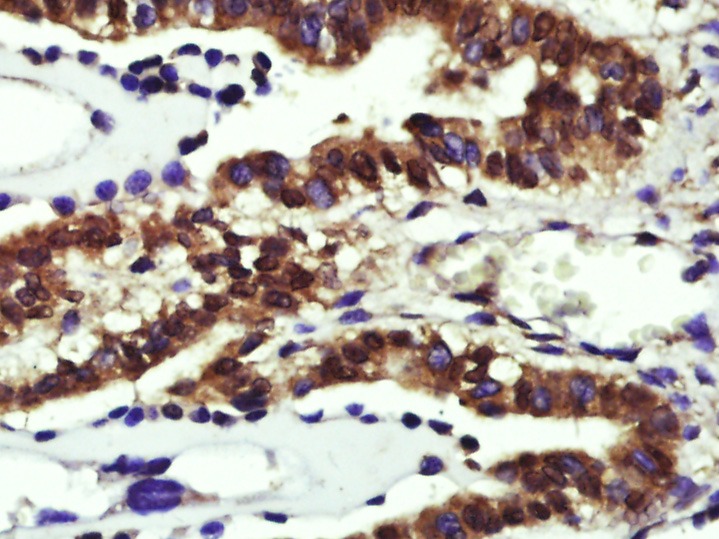

购物车
 您的购物车当前为空
您的购物车当前为空
Anti-CCND1 Polyclonal Antibody 2 是一种 Rabbit 抗体,靶向 CCND1。Anti-CCND1 Polyclonal Antibody 2 可用于 FCM, ICC/IF, IF, IHC-Fr, IHC-P。
别名 PRAD1 oncogene, PRAD1, G1/S-specific cyclin-D1, CCND1, BCL-1 oncogene, BCL1, B-cell lymphoma 1 protein (BCL-1)
Anti-CCND1 Polyclonal Antibody 2 是一种 Rabbit 抗体,靶向 CCND1。Anti-CCND1 Polyclonal Antibody 2 可用于 FCM, ICC/IF, IF, IHC-Fr, IHC-P。
| 规格 | 价格 | 库存 | 数量 |
|---|---|---|---|
| 50 μL | ¥ 1,160 | 5日内发货 | |
| 100 μL | ¥ 1,960 | 5日内发货 | |
| 200 μL | ¥ 2,785 | 5日内发货 |
TargetMol的所有产品仅用作科学研究或药证申报,不能被用于人体,我们不向个人提供产品和服务。请您遵守承诺用途,不得违反法律法规规定用于任何其他用途。
| 产品描述 | Anti-CCND1 Polyclonal Antibody 2 is a Rabbit antibody targeting CCND1. Anti-CCND1 Polyclonal Antibody 2 can be used in FCM, ICC/IF, IF, IHC-Fr, IHC-P. |
| 别名 | PRAD1 oncogene, PRAD1, G1/S-specific cyclin-D1, CCND1, BCL-1 oncogene, BCL1, B-cell lymphoma 1 protein (BCL-1) |
| Ig Type | IgG |
| 反应种属 | Human,Mouse,Rat |
| 验证活性 | 1. A431 cell; 4% Paraformaldehyde-fixed; Triton X-100 at room temperature for 20 min; Blocking buffer (normal goat serum) at 37°C for 20 min; Antibody incubation with (Cyclin D1) polyclonal Antibody, Unconjugated (TMAB-00318) 1:100, 90 minutes at 37°C; followed by a conjugated Goat Anti-Rabbit IgG antibody at 37°C for 90 minutes, DAPI (blue) was used to stain the cell nucleus. 2. Paraformaldehyde-fixed, paraffin embedded (Mouse placenta); Antigen retrieval by boiling in sodium citrate buffer (pH6.0) for 15 min; Block endogenous peroxidase by 3% hydrogen peroxide for 20 min; Blocking buffer (normal goat serum) at 37°C for 30 min; Antibody incubation with (Cyclin D1) Polyclonal Antibody, Unconjugated (TMAB-00318) at 1:400 overnight at 4°C, followed by operating according to SP Kit (Rabbit) instructionsand DAB staining. 3. Paraformaldehyde-fixed, paraffin embedded (Mouse brain); Antigen retrieval by boiling in sodium citrate buffer (pH6.0) for 15 min; Block endogenous peroxidase by 3% hydrogen peroxide for 20 min; Blocking buffer (normal goat serum) at 37°C for 30 min; Antibody incubation with (Cyclin D1) Polyclonal Antibody, Unconjugated (TMAB-00318) at 1:400 overnight at 4°C, followed by operating according to SP Kit (Rabbit) instructionsand DAB staining. 4. Blank control (blue line): MCF 7 (fixed with 70% methanol (Overnight at 4°C) and then permeabilized with 90% ice-cold methanol for 30 min on ice). Primary Antibody (green line): Rabbit Anti-Cyclin D1 antibody (TMAB-00318), Dilution: 3 μg/10^5 cells; Isotype Control Antibody (orange line): Rabbit IgG. Secondary Antibody (white blue line): Goat anti-rabbit IgG-FITC, Dilution: 1 μg/test. 5. Paraformaldehyde-fixed, paraffin embedded (rat uterus); Antigen retrieval by boiling in sodium citrate buffer (pH6.0) for 15 min; Block endogenous peroxidase by 3% hydrogen peroxide for 20 min; Blocking buffer (normal goat serum) at 37°C for 30 min; Antibody incubation with (Cyclin D1) Polyclonal Antibody, Unconjugated (TMAB-00318) at 1:200 overnight at 4°C, followed by operating according to SP Kit (Rabbit) instructionsand DAB staining. 6. Paraformaldehyde-fixed, paraffin embedded (mouse kidney); Antigen retrieval by boiling in sodium citrate buffer (pH6.0) for 15 min; Block endogenous peroxidase by 3% hydrogen peroxide for 20 min; Blocking buffer (normal goat serum) at 37°C for 30 min; Antibody incubation with (Cyclin D1) Polyclonal Antibody, Unconjugated (TMAB-00318) at 1:200 overnight at 4°C, followed by operating according to SP Kit (Rabbit) instructionsand DAB staining. 7. Paraformaldehyde-fixed, paraffin embedded (rat kidney); Antigen retrieval by boiling in sodium citrate buffer (pH6.0) for 15 min; Block endogenous peroxidase by 3% hydrogen peroxide for 20 min; Blocking buffer (normal goat serum) at 37°C for 30 min; Antibody incubation with (Cyclin D1) Polyclonal Antibody, Unconjugated (TMAB-00318) at 1:200 overnight at 4°C, followed by operating according to SP Kit (Rabbit) instructionsand DAB staining. 8. Paraformaldehyde-fixed, paraffin embedded (rat liver); Antigen retrieval by boiling in sodium citrate buffer (pH6.0) for 15 min; Block endogenous peroxidase by 3% hydrogen peroxide for 20 min; Blocking buffer (normal goat serum) at 37°C for 30 min; Antibody incubation with (Cyclin D1) Polyclonal Antibody, Unconjugated (TMAB-00318) at 1:200 overnight at 4°C, followed by operating according to SP Kit (Rabbit) instructionsand DAB staining. 9. Paraformaldehyde-fixed, paraffin embedded (mouse liver); Antigen retrieval by boiling in sodium citrate buffer (pH6.0) for 15 min; Block endogenous peroxidase by 3% hydrogen peroxide for 20 min; Blocking buffer (normal goat serum) at 37°C for 30 min; Antibody incubation with (Cyclin D1) Polyclonal Antibody, Unconjugated (TMAB-00318) at 1:200 overnight at 4°C, followed by operating according to SP Kit (Rabbit) instructionsand DAB staining. 10. Paraformaldehyde-fixed, paraffin embedded (Rat liver); Antigen retrieval by boiling in sodium citrate buffer (pH6.0) for 15 min; Block endogenous peroxidase by 3% hydrogen peroxide for 20 min; Blocking buffer (normal goat serum) at 37°C for 30 min; Antibody incubation with (Cyclin D1) Polyclonal Antibody, Unconjugated (TMAB-00318) at 1:500 overnight at 4°C, followed by a conjugated secondary for 20 min and DAB staining. |
| 应用 | FCMICC/IFIFIHC-FrIHC-P |
| 推荐剂量 | FCM=3 μg/Test; ICC/IF=1:100-500; IF=1:100-500; IHC-Fr=1:100-500; IHC-P=1:100-500 |
| 抗体种类 | Polyclonal |
| 宿主来源 | Rabbit |
| 亚细胞定位 | Nucleus. Cytoplasm. Membrane. Note=CyclinD-CDK4 complexes accumulate at the nuclear membrane and are thentranslocated to the nucleus through interaction with KIP/CIP familymembers. |
| 构建方式 | Polyclonal Antibody |
| 纯化方式 | Protein A purified |
| 性状 | Liquid |
| 缓冲液 | 0.01M TBS (pH7.4) with 1% BSA, 0.02% Proclin300 and 50% Glycerol. |
| 浓度 | 1 mg/mL |
| 研究背景 | The protein encoded by this gene belongs to the highly conserved cyclin family, whose members are characterized by a dramatic periodicity in protein abundance throughout the cell cycle. Cyclins function as regulators of CDK kinases. Different cyclins exhibit distinct expression and degradation patterns which contribute to the temporal coordination of each mitotic event. This cyclin forms a complex with and functions as a regulatory subunit of CDK4 or CDK6, whose activity is required for cell cycle G1/S transition. This protein has been shown to interact with tumor suppressor protein Rb and the expression of this gene is regulated positively by Rb. Mutations, amplification and overexpression of this gene, which alters cell cycle progression, are observed frequently in a variety of tumors and may contribute to tumorigenesis. [provided by RefSeq, Jul 2008]. |
| 免疫原 | KLH conjugated synthetic peptide: human Cyclin D1 |
| 抗原种属 | Human |
| 基因名称 | CCND1 |
| 基因ID | |
| 蛋白名称 | G1/S-specific cyclin-D1 |
| Uniprot ID | |
| 研究领域 | Cyclin D family,Cyclin D Family,Cyclin D Family |
| 功能 | Regulatory component of the cyclin D1-CDK4 (DC) complexthat phosphorylates and inhibits members of the retinoblastoma (RB)protein family including RB1 and regulates the cell-cycle duringG(1)/S transition. Phosphorylation of RB1 allows dissociation ofthe transcription factor E2F from the RB/E2F complex and thesubsequent transcription of E2F target genes which are responsiblefor the progression through the G(1) phase. Hypophosphorylates RB1in early G(1) phase. Cyclin D-CDK4 complexes are major integratorsof various mitogenenic and antimitogenic signals. Also substratefor SMAD3, phosphorylating SMAD3 in a cell-cycle-dependent mannerand repressing its transcriptional activity. Component of theternary complex, cyclin D1/CDK4/CDKN1B, required for nucleartranslocation and activity of the cyclin D-CDK4 complex. |
| 分子量 | Theoretical: 32 kDa. |
| 储存方式 | Store at -20°C or -80°C for 12 months. Avoid repeated freeze-thaw cycles. |
| 运输方式 | Shipping with blue ice. |